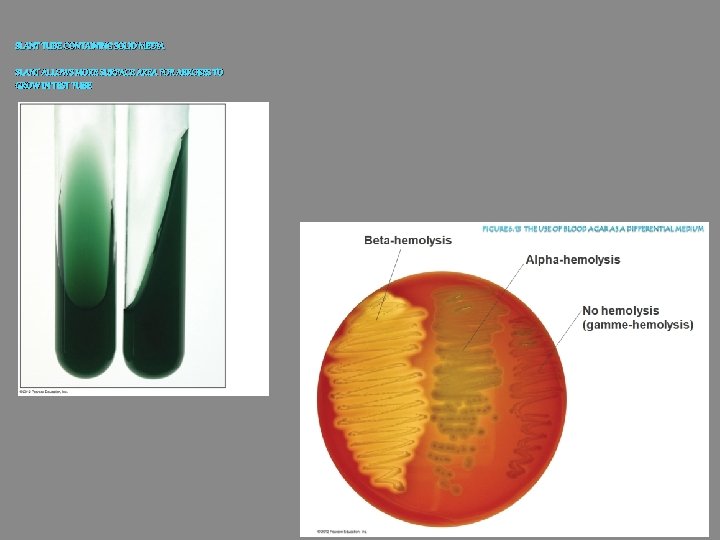
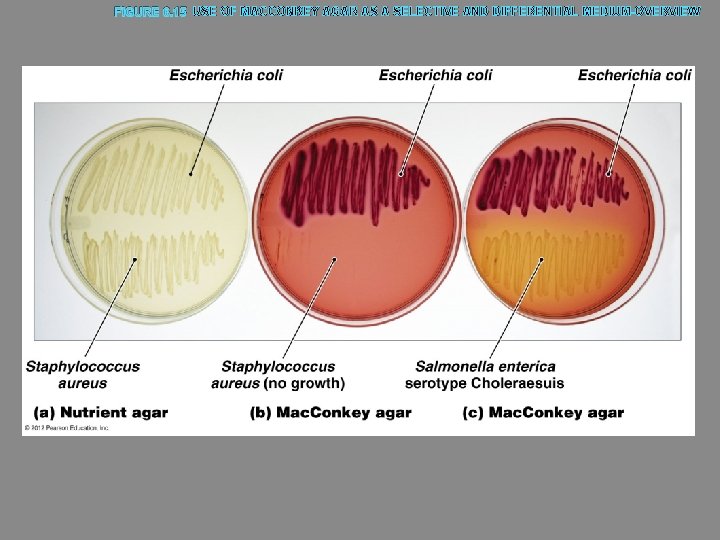

Chapter 6 Microbial Nutrition and Growth Growth Requirements

Chapter 6 Microbial Nutrition and Growth

Growth Requirements Microbial growth Increase in a population of microbes Result of microbial growth is discrete colony An aggregation of cells arising from single parent cell Reproduction results in growth © 2012 Pearson Education Inc.

Growth Requirements Organisms use a variety of nutrients for their energy needs and to build organic molecules and cellular structures Most common nutrients contain necessary elements such as carbon, oxygen, nitrogen, and hydrogen Microbes obtain nutrients from variety of sources © 2012 Pearson Education Inc.

Growth Requirements Nutrients: Chemical and Energy Requirements Sources of carbon, energy, and electrons ○ Two groups of organisms based on source of carbon Autotrophs Heterotrophs ○ Two groups of organisms based on source of energy Chemotrophs Phototrophs © 2012 Pearson Education Inc.

FIGURE 6. 1 FOUR BASIC GROUPS OF ORGANISMS

Growth Requirements Nutrients: Chemical and Energy Requirements Oxygen requirements ○ Oxygen is essential for obligate aerobes ○ Oxygen is deadly for obligate anaerobes How can this be true? - O 2 and oxygen in compounds are not toxic - However, toxic forms of oxygen are highly reactive and excellent oxidizing agents (same reason why oxygen is excellent electron acceptor in electron transport chain) - Resulting oxidation causes irreparable damage to cells - Obligate anaerobes don’t have enzymes to deal with these toxic forms of oxygen © 2012 Pearson Education Inc.

Growth Requirements Nutrients: Chemical and Energy Requirements Oxygen requirements ○ Four toxic forms of oxygen Singlet oxygen - Can be formed during aerobic respiration, some organisms have enzymes to deal with this Superoxide radicals Peroxide anion Hydroxyl radical © 2012 Pearson Education Inc.

Growth Requirements Nutrients: Chemical and Energy Requirements Oxygen requirements ○ Aerobes ○ Anaerobes ○ Facultative anaerobes Can grow without oxygen but growth is enhanced with it ○ Aerotolerant anaerobes Are not bothered by presence of oxygen ○ Microaerophiles Need lower % oxygen © 2012 Pearson Education Inc.

Growth Requirements Nutrients: Chemical and Energy Requirements Nitrogen requirements ○ Anabolism often ceases because of insufficient nitrogen ○ Nitrogen acquired from organic and inorganic nutrients ○ All cells recycle nitrogen from amino acids and nucleotides ○ Nitrogen fixation by certain bacteria is essential to life on Earth © 2012 Pearson Education Inc.

Growth Requirements Nutrients: Chemical and Energy Requirements Other chemical requirements ○ Phosphorus ○ Sulfur ○ Trace elements – vitamins, minerals, etc Required only in small amounts ○ Growth factors Necessary organic chemicals that cannot be synthesized by certain organisms © 2012 Pearson Education Inc.

Growth Requirements Physical Requirements Temperature ○ Effect of temperature on proteins ○ Effect of temperature on membranes of cells and organelles If too low, membranes become rigid and fragile If too high, membranes become too fluid © 2012 Pearson Education Inc.


Growth Requirements Physical Requirements p. H ○ Organisms are sensitive to changes in acidity H+ and OH– interfere with H bonding ○ Neutrophiles grow best in a narrow range around neutral p. H ○ Acidophiles grow best in acidic habitats ○ Alkalinophiles live in alkaline soils and water © 2012 Pearson Education Inc.

Growth Requirements Physical effects of water ○ Microbes require water to dissolve enzymes and nutrients ○ Water is important reactant in many metabolic reactions ○ Most cells die in absence of water Some have cell walls that retain water Endospores and cysts cease most metabolic activity ○ Two physical effects of water Osmotic pressure Hydrostatic pressure © 2012 Pearson Education Inc.

Growth Requirements Physical Requirements Physical effects of water ○ Osmotic pressure Pressure exerted on a semipermeable membrane by a solution containing solutes that cannot freely cross membrane Hypotonic solutions have lower solute concentrations Hypertonic solutions have greater solute concentrations Restricts organisms to certain environments - Obligate and facultative halophiles © 2012 Pearson Education Inc.

Growth Requirements Physical Requirements Physical effects of water ○ Hydrostatic pressure Water exerts pressure in proportion to its depth Barophiles live under extreme pressure - Their membranes and enzymes depend on pressure to maintain their shape © 2012 Pearson Education Inc.

Growth Requirements Associations and Biofilms Organisms live in association with different species ○ Antagonistic relationships - One organism is harmed or killed ○ Synergistic relationships - Organisms are benefited by relationship but can live fine on their own ○ Symbiotic relationships - Organisms are interdependent © 2012 Pearson Education Inc.

Growth Requirements Associations and Biofilms ○ Complex relationships among numerous microorganisms ○ Develop an extracellular matrix Adheres cells to one another Allows attachment to a substrate Sequesters nutrients May protect individuals in the biofilm ○ Form on surfaces often as a result of quorum sensing ○ Many microorganisms more harmful as part of a biofilm © 2012 Pearson Education Inc.

Culturing Microorganisms Inoculum (specimen) introduced into medium Environmental specimens Clinical specimens Stored specimens Culture Act of cultivating microorganisms or the microorganisms that are cultivated © 2012 Pearson Education Inc.

FIGURE 6. 8 CHARACTERISTICS OF BACTERIAL COLONIES-OVERVIEW

Culturing Microorganisms Figure 6. 10 Pour plate method of isolation-overview Obtaining Pure Cultures composed of cells arising from a single progenitor ○ Progenitor is termed a CFU (colony forming unit) COLONY – group of bacteria arising from a single bacteria (in other words – a bunch of clones) Aseptic technique prevents contamination of sterile substances or objects Two common isolation techniques: ○ Streak plates ○ Pour plates © 2012 Pearson Education Inc.

Culturing Microorganisms Culture Media Majority of prokaryotes have not been grown in culture medium Six types of general culture media ○ Defined media - Synthetic, exact chemical composition is known ○ Complex media - Contains nutrients that are released by partial digestion of yeast, beef, soy - Used to grow organisms whose exact nutritional needs are not known - TSA, Mac. Conkey, nutrient broth, blood is sometimes added ○ Selective media - Either favors growth of particular organism or inhibits ○ Differential media - Differences in change in media or colony color can be seen ○ Anaerobic media ○ Transport media - Depends on sample and suspected organism © 2012 Pearson Education Inc.
SLANT TUBE CONTAINING SOLID MEDIA SLANT ALLOWS MORE SURFACE AREA FOR AEROBES TO GROW IN TEST TUBE
FIGURE 6. 15 USE OF MACCONKEY AGAR AS A SELECTIVE AND DIFFERENTIAL MEDIUM-OVERVIEW


Culturing Microorganisms Special Culture Techniques developed for culturing microorganisms ○ Animal and cell culture ○ Low-oxygen culture CO 2 incubators ○ Enrichment culture Uses selective media to enhance #’s of a particular organism in mixed sample © 2012 Pearson Education Inc.

Culturing Microorganisms Preserving Cultures Refrigeration ○ Stores for short periods of time Deep-freezing ○ Stores for years Lyophilization - removing water from frozen culture ○ Stores for decades © 2012 Pearson Education Inc.

FIGURE 6. 17 BINARY FISSION EVENTS-OVERVIEW

COMPARISON OF ARITHMETIC AND LOGARITHMIC GROWTH-OVERVIEW

Growth of Microbial Populations Generation Time required for a bacterial cell to grow and divide Dependent on chemical and physical conditions © 2012 Pearson Education Inc.

Number of live cells (log) FIGURE 6. 20 TYPICAL MICROBIAL GROWTH CURVE Stationary phase Log (exponential) phase Lag phase Time Death (decline) phase


Growth of Microbial Populations Measuring Microbial Reproduction Direct methods ○ Serial dilution and viable plate counts ○ Membrane filtration ○ Most probable number ○ Microscopic counts ○ Electronic counters © 2012 Pearson Education Inc.

ESTIMATING MICROBIAL POPULATION SIZE-OVERVIEW


USE OF MEMBRANE FILTRATION TO ESTIMATE MICROBIAL POPULATION-OVERVIEW

THE USE OF A CELL COUNTER FOR ESTIMATING MICROBIAL NUMBERS-OVERVIEW

Growth of Microbial Populations Measuring Microbial Growth Indirect methods ○ Metabolic activity under standard conditions ○ Dry weight Filamentous organisms difficult to count; dry and weigh ○ Turbidity © 2012 Pearson Education Inc.

Growth of Microbial Populations Measuring Microbial Reproduction Genetic methods ○ Isolate DNA sequences of unculturable prokaryotes Majority of bacteria and archaea cannot be grown in lab Used to estimate the number of these microbes © 2012 Pearson Education Inc.
- Slides: 39